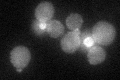
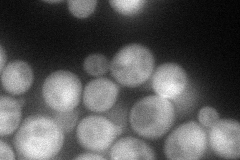
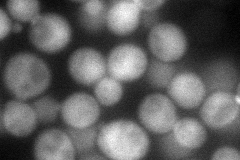
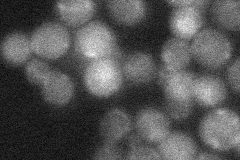
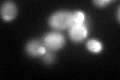

View description
Serine/threonine protein kinase that regulates cell morphogenesis pathways; involved in cell wall biosynthesis, apical growth, proper mating projection morphology, bipolar bud site selection in diploid cells, and cell separation
Localization:
Intensity:
Fold change:
Significance:
-
C’ GFP library in SD
cytosol:bud neckN/A -
N' NOP1pr-GFP in SD
cytosol,bud neck79.7085 -
N' TEF2pr-mCherry in SD
punctate,bud neck79.3014 -
N' NATIVEpr-GFP in SD
bud neck21.907 -
N' TEF2pr-VC and Cyto-VN in SD

#N/A0 -
C’ GFP library in SD+DTT
cytosol.bud neckN/AN/ANo -
C’ GFP library in SD+H2O2

technical problem0N/ANo -
C’ GFP library in Starvation Media

cytosol,bud neckN/AN/AYes -
C’ GFP library on the background of Pup2-DaMP

cytosol:bud neck -
C’ GFP library on the background of CCT mutant

cytosol:bud neckN/AN/ANo
